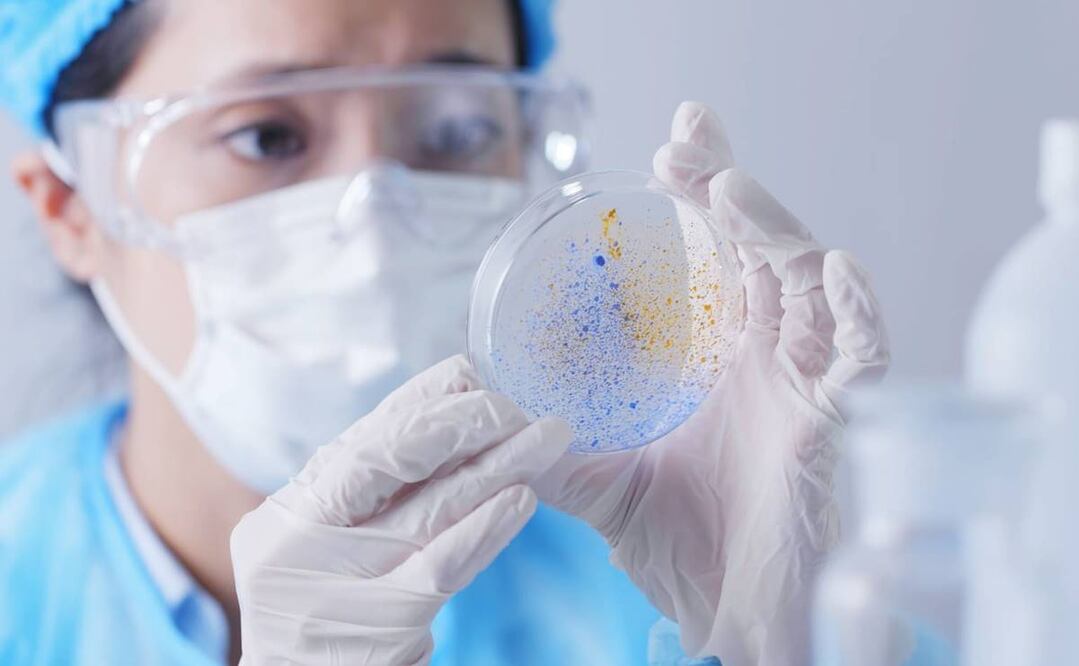
Foto: Archivo/EL UNIVERSAL

Más Información

Plan B de reforma electoral va al Senado, anuncia Sheinbaum; en esto consiste el proyecto de la Presidenta

FGR tiene su opinión: Sheinbaum sobre falta de resguardo a cabañas de “El Mencho”; Ernestina Godoy debe explicar, indica

UNAM crea Consejo Coordinador de Inteligencia Artificial; busca salvaguardar la integridad académica y la propiedad intelectual

"Puede ser, vamos a ver"; es posible que en la próxima legislatura envíe reforma para pluris, adelanta Sheinbaum

Pase de charola de AMLO enfrenta a embajadores de Cuba y EU; Johnson condena "régimen opresor" y le reviran "el pueblo cubano es libre"
Diez mil personas han dado positivo a brucelosis en el noroeste de China , revelaron funcionarios del gobierno municipal de la ciudad de Lanzhou, citados por la cadena de noticias CNN.
El brote comenzó en 2019, por la fuga de una bacteria de la planta biofarmacéutica de Zhongmu Lanzhou, que produce vacunas para animales, dijeron las autoridades.
La brucelosis es una enfermedad transmitida por el ganado o los productos animales. Generalmente no es contagiosa entre los humanos pero puede provocar fiebre , dolor en las articulaciones y dolores de cabeza.
Hasta el 5 de noviembre se habían registrado seis mil 620 casos de brucelosis, pero la nueva cifra indica que el brote continúa.
También lee
: "Yo también he muerto": el dolor persiste en Wuhan, a más de un año del brote de Covid-19
Las autoridades habían explicado que el laboratorio usó un desinfectante caducado en julio y agosto de 2019 en la producción de vacunas contra la brucelosis para animales.
Como resultado, la esterilización fue incompleta y las bacterias todavía estaban presentes en las emisiones de gas de la compañía.
También lee
: Más del 70% de enfermos de Covid-19 curados en Wuhan, con síntomas después: estudio
El gas contaminado se propagó por el aire hasta el cercano Instituto de Investigación Veterinaria, donde infectó a casi 200 personas en diciembre de 2019.
La bacteria suele proceder de ovejas, vacas o cerdos. El laboratorio se disculpó y se le revocó a licencia para producir vacunas contra la brucelosis.
También lee
: Wuhan, la ciudad que pasó de ser foco del Covid a un destino turístico de primera
Las autoridades de Lanzhou prometieron compensación económica a las personas que han enfermado por este brote.
***Con información de AFP
Más Información
Noticias según tus intereses
ViveUSA
[Publicidad]